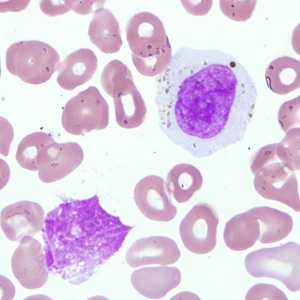

Case #238 - October, 2008
A 45-year-old man from Kenya who was visiting relatives in the New England area had complaints of fever and headache. He was taken to a nearby hospital for medical evaluation. A Giemsa-stained thin blood smear was prepared and examined at 1000x magnification. Figures A and B show what was observed in low numbers on the smear. What is your diagnosis? Based on what criteria? What, if any, other tests should be performed?
Figure A

Figure B
Case Answer
The objects shown in the figures were white blood cells, but contained ingested pigment (black arrows, Figures A and B) from Plasmodium sp. parasites. Detection of pigment in macrophages can be an indicator of the presence of Plasmodium sp. In cases where the number of parasites is very low, a thick smear can prove helpful in demonstrating the presence of parasites. It is recommended that both thick and thin blood smears be prepared, and at least 300 fields at 1000x magnification be examined as routine. If no parasites are found, follow-up smears should be prepared and examined over a 36-hour period. In this case, a second smear was prepared, stained, and examined, and rare ring-stage parasites were found. The use of molecular techniques such as PCR can also be very helpful to determine the species of Plasmodium, and thus facilitate the most appropriate treatment regimen. Figure C shows and example of what was found on the follow-up smear. The black arrows indicate ingested pigment; the blue arrow indicates a single ring-stage parasite.
More on: Malaria
Images presented in the monthly case studies are from specimens submitted for diagnosis or archiving. On rare occasions, clinical histories given may be partly fictitious.
DPDx is an education resource designed for health professionals and laboratory scientists. For an overview including prevention and control visit www.cdc.gov/parasites/.
- Page last reviewed: August 24, 2016
- Page last updated: August 24, 2016
- Content source:
- Global Health – Division of Parasitic Diseases and Malaria
- Notice: Linking to a non-federal site does not constitute an endorsement by HHS, CDC or any of its employees of the sponsors or the information and products presented on the site.
- Maintained By:


 ShareCompartir
ShareCompartir